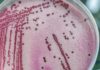
Groźna bakteria w jasielskim szpitalu! W piątek Sanepid pobierze kolejne próbki

Przedświąteczny tydzień w Gimnazjum nr 2 z O. I. w Jaśle był okresem wzmożonej dyskusji na temat ochrony środowiska w naszym regionie. Debaty, które odbyły się w szkole z udziałem zaproszonych gości poruszały różne dziedziny ekologii, a wszystko pod hasłem XIX Sesji Sejmu Dzieci i Młodzieży „Lokalny EKOrozwój”.
Uczniowie Gimnazjum Nr 2 w Jaśle po raz kolejny stanęli na wysokości zadania. Po raz czwarty przygotowali cztery różne debaty, tym razem zajmujące się zagadnieniem ochrony środowiska w naszym regionie. Rozmowy dotyczyły tego co zrobiono do tej pory, przestrzeni wokół nas i energii odnawialnej, transportu oraz ekologicznych zakupów i świadomej konsumpcji.
W poszczególnych debatach uczestniczyli: przewodnicząca Komisji Samorządu i Ochrony Środowiska RMJ pani Krystyna Sikora, radna Miasta Jasła zajmująca się od lat problematyką ekologii Maria Filip – Niwelt, dyrekcja szkoły, uczniowie i nauczyciele gimnazjów i szkół ponadgimnazjalnych, przedstawiciele: Młodzieżowego Domu Kultury, Jasielskiego Stowarzyszenia CONSENSUS, Stowarzyszenia Miłośników Jasła i Regionu Jasielskiego, Powiatowego Młodzieżowego Centrum Wolontariatu w Jaśle, Komendy Hufca ZHP w Jaśle, 139. Drużyny Harcerskiej „Lisy” oraz członkowie Samorządu Uczniowskiego Gimnazjum Nr 2 w Jaśle.
Każdy z zespołów miał ważne zadanie – nie tylko przeprowadzić debatę, ale przede wszystkim uzmysłowić, jak powinniśmy żyć na co dzień, aby nie niszczyć naszego środowiska i tym samym nie niszczyć samych siebie.
Młodzież i goście podawali wiele przykładów oraz wniosków, m.in.:
– zwiększenie akcji edukacyjnych w szkołach i być może w przedszkolach,
– poruszanie się komunikacja miejską dla ograniczenia wydzielania spalin lub rowerem,
– popieranie budowy ścieżek rowerowych w mieście, przeprowadzenie akcji informacyjnej o korzyściach z tego wynikających,
– akcja edukacyjna w szkołach/szkole na temat świadomych zakupów,
– edukacja od najmłodszych lat pod hasłem „Jak się ekologicznie zachowywać w miejscach publicznych?”,
– wspieranie akcji edukacyjnych władz lokalnych zachęcających do segregacji surowców wtórnych,
– organizacja happeningów ekologicznych wraz z wolontariatem.
– Mamy nadzieję, że nasze plany i zamiary uda się zrealizować jak najszybciej, choć zmiany zawsze są trudne. Wiele już zostało zrobione, dołóżmy w tym dziele kolejną cegiełkę. Postarajmy się zacząć od rzeczy prostych: nie zaśmiecajmy naszego „podwórka”, starajmy się być tolerancyjni i otwarci na wspólne działania, chciejmy się uczyć na czym powinna polegać praktyczna służba ekologiczna na rzecz swojego środowiska lokalnego – mówią uczniowie Gimnazjum nr 2. – Po prostu CHCIEJMY. I tym hasłem zacznijmy nasze działanie: Twoje, moje, nasze…
dr
{gallery}galerie/sejm_dzieci{/gallery}